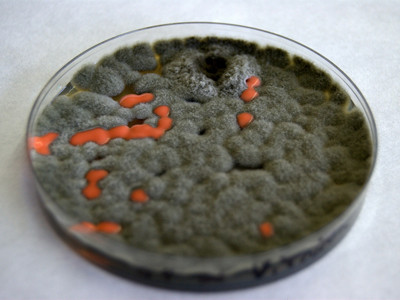
Vui nhộn đĩa Petri trên Google 31/5

>Hướng dẫn nhắn tin và gọi điện miễn phí trên Google
Julius Richard Petri (31/5/1852 - 20/12/1921) là nhà vi khuẩn học người Đức, thường được coi là người phát minh ra đĩa Petri khi làm việc với tư cách trợ lý cho bác sỹ người Đức Robert Koch.
Petri khởi đầu sự nghiệp bằng việc nghiên cứu y khoa tại Học viện y khoa quân sự Kaiser-Wilhelm (1871-1875) và nhận bằng y khoa vào năm 1876. Ông tiếp tục nghiên cứu tại Bệnh viện Charité ở Berlin và đảm nhận vai trò là một bác sĩ quân y cho đến năm 1882. Ông là người đã phát kiến ra đĩa Petri, dụng cụ để nghiên cứu vi sinh vật mà ngày nay tên của ông được dùng để đặt cho dụng cụ này.
| |
Một đĩa Petri là một thiết bị quen thuộc trong phòng thí nghiệm vi sinh học, được làm bằng kính trong suốt hoặc nhựa. Nó là một đĩa cạn với đáy bằng phẳng, viền xung quanh dựng đứng và uốn cong tạo thành vòng tròn. Đĩa có nắp lớn hơn một chút, đậy kín vành đĩa.
Đĩa Petri tuy đơn giản nhưng là bước đột phá trong nghiên cứu hóa học, vi sinh vật học và y tế.
Quỳnh Nga
Video: youtube